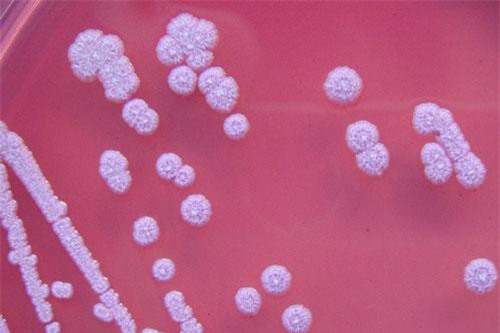
Mọi thông tin về căn bệnh "nhiễm khuẩn ăn thịt người" - Whitmore, đặc biệt là cách phòng ngừa cần lưu ý

Tìm kiếm: dấu-hiệu-mắc-bệnh
DNVN - Mặc dù cơ quan công an các tỉnh, thành đã triệu tập hơn 170 đối tượng, xử lý, yêu cầu cam kết gỡ bỏ tin sai, tin giả về dịch bệnh do virus Corona trên mạng xã hội, hơn 40 trường hợp khác cũng đang được làm rõ, nhưng tin giả vẫn tiếp tục được tung ra trên môi trường mạng.
Từ ngày 11 - 23/12, Bệnh viện đa khoa tỉnh Điện Biên thực hiện xét nghiệm 453 ca nghi ngờ mắc cúm, trong đó phát hiện 164 ca dương tính với virus cúm A, virus cúm B.
Hiện nay vẫn chưa có vắc-xin phòng bệnh Whitmore nên muốn phòng bệnh, bạn cần lưu ý các điều sau.
Theo Bách khoa thư mở (VWO), tính đến hết tháng 3/2018, tổng dân số Trái Đất ước tính 7,61 tỉ người. Đứng đầu là Trung Quốc (1,415 tỷ) và đứng cuối là Quần đảo Pitcairn với 50 người.
Bị vợ đòi ly hôn, Nguyễn An Tuấn bực tức, nã đạn vào bốn người song ngày ra tòa anh ta trốn dưới gầm bàn vì sợ "ma bắt".
Nổ súng bắn cả nhà vợ, ra đến tòa, Nguyễn Anh Tuấn có những hành động vô cùng kỳ quặc...
Đó là quy định mới trong Luật thi hành tạm giữ, tạm giam số 94/2015/QH13 ngày 25/11/2015, được Quốc hội thông qua và chính thức có hiệu lực từ 1/1/2018.
Ông Đinh La Thăng đã bị bắt tạm giam. Điều mà dư luận quan tâm là ông Thăng sẽ bị áp dụng chế độ gì?
Trước tình hình dịch bệnh sốt xuất huyết (SXH) đang diễn biến phức tạp, Thủ tướng vừa có công điện về việc tăng cường công tác phòng chống SXH.
Chỉ trong 2 tháng đầu năm, số ca mắc bệnh ho gà những tháng đầu năm 2017 đã gia tăng tại một số tỉnh thành phố phía Bắc. Đáng tiếc, đã có 5 trẻ tử vong do căn bệnh này.
Sau khi xuất hiện dịch bệnh bạch hầu bùng phát tại trường cấp 3 trên địa bàn huyện Tây Giang khiến 2 học sinh tử vong. Bộ Y tế đã đưa ra khuyến cáo phòng bệnh bạch hầu gấp.
(DNVN) - Người dân hốt hoảng phát hiện một thi thể một phụ nữ cháy đen dưới chân đồi nên nhanh chóng báo cho chính quyền địa phương và các ngành chức năng.
(DNVN) - Theo Cục Y tế dự phòng (Bộ Y tế), bệnh bạch hầu là bệnh nhiễm khuẩn, nhiễm độc cấp tính do vi khuẩn bạch hầu gây nên; bệnh thường gặp ở trẻ nhỏ, tuy nhiên cũng có thể gặp ở người lớn nếu không có miễn dịch.
(DNVN) - Thời tiết nắng nóng gay gắt liên tục tại Đà Nẵng làm nhiều trẻ em nhập viện ồ ạt, dẫn đến tình trạng quá tải khiến công tác khám, điều trị gặp nhiều khó khăn.
Cho rằng người cõi âm "yêu", người đàn ông tại tỉnh Quảng Nam đã tự ý cắt lìa “của quý” khiến nhiều người ngỡ ngàng.
End of content
Không có tin nào tiếp theo